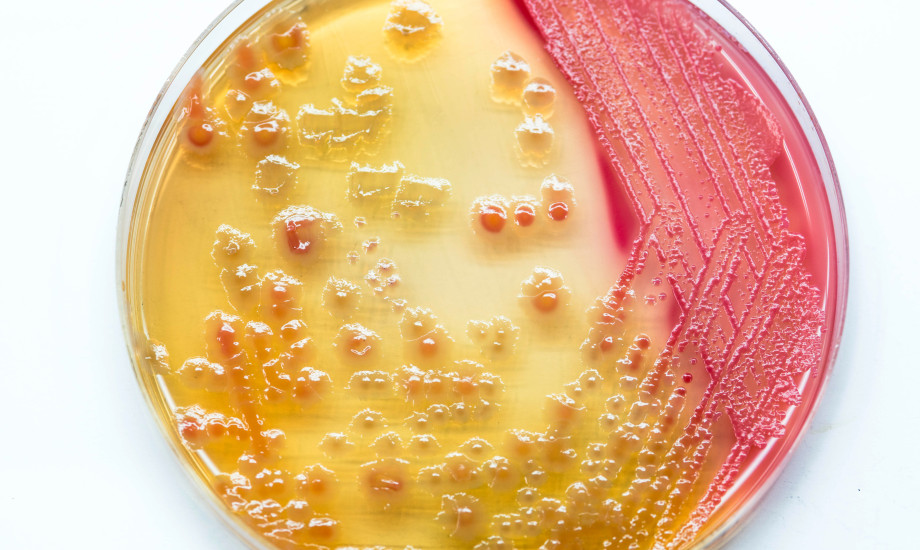

Präoperative Urinkultur und Antibiotika senken Infektionsrisiko nicht
Eine kürzlich durchgeführte große Kohortenstudie legt nahe, dass die Praxis der präoperativen Urinkultur das Risiko für postoperative Harnwegsinfektionen oder Infektionen an der Operationsstelle möglicherweise nicht signifikant reduziert.
© analysis121980 / stock.adobe.com
© analysis121980 / stock.adobe.com 

Zerbor_adobe_285788836.jpg)
 Yantra, adobe_1876456709.jpg)










_513841503.jpeg)




